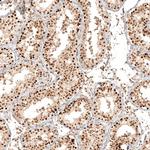
KIAA1551 Antibody in Immunohistochemistry (Paraffin) (IHC (P))

Search
Invitrogen
KIAA1551 Polyclonal Antibody
{{$productOrderCtrl.translations['antibody.pdp.commerceCard.promotion.promotions']}}
{{$productOrderCtrl.translations['antibody.pdp.commerceCard.promotion.viewpromo']}}
{{$productOrderCtrl.translations['antibody.pdp.commerceCard.promotion.promocode']}}: {{promo.promoCode}} {{promo.promoTitle}} {{promo.promoDescription}}. {{$productOrderCtrl.translations['antibody.pdp.commerceCard.promotion.learnmore']}}
产品信息
PA5-53091
种属反应
宿主/亚型
分类
类型
抗原
偶联物
形式
浓度
规格
纯化类型
保存液
内含物
保存条件
运输条件
RRID
产品详细信息
Immunogen sequence: LTKLESSPRK LHKDKRQENK HKTFLPVKGN TEKSNMLEFK LCPDILLKNT NSVEERKDVK PHPRKEQAPL QVSGIKSTKE DWLKFVATKK RTQKDSQERD NVNSRLSKRS FSADGFEMLQ NPVKDSKEMF QTY
Highest antigen sequence identity to the following orthologs: Mouse - 57%, Rat - 59%.
靶标信息
Plays a role in the regulation of imprinted gene expression, regulates repressive epigenetic modifications associated with SETDB1. Required for the recruitment or accumulation of SETDB1 to the endogenous retroviruses (ERVs) and maintenance of repressive chromatin configuration, contributing to a subset of the SETDB1-dependent ERV silencing in embryonic stem cells. [UniProt]
仅用于科研。不用于诊断过程。未经明确授权不得转售。
篇参考文献 (0)
生物信息学
蛋白别名: gonad expressed transcript; Retroelement silencing factor 1; uncharacterized protein C12orf35; unnamed protein product
基因别名: C12orf35; GET; KIAA1551; RESF1; UTA2-1
UniProt ID: (Human) Q9HCM1
Entrez Gene ID: (Human) 55196